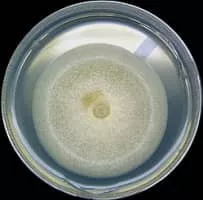
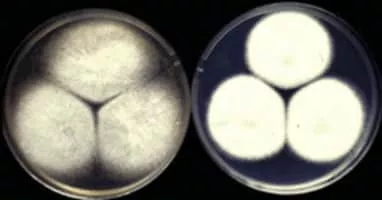

Aspergillus Nidulans
| Use attributes for filter ! | |
| Scientific name | Aspergillus nidulans |
|---|---|
| Rank | Species |
| Higher classification | Aspergillus |
| Class | Eurotiomycetes |
| Date of Reg. | |
| Date of Upd. | |
| ID | 952000 |
About Aspergillus Nidulans
Aspergillus nidulans is one of many species of filamentous fungi in the phylum Ascomycota. It has been an important research organism for studying eukaryotic cell biology for over 50 years, being used . . .